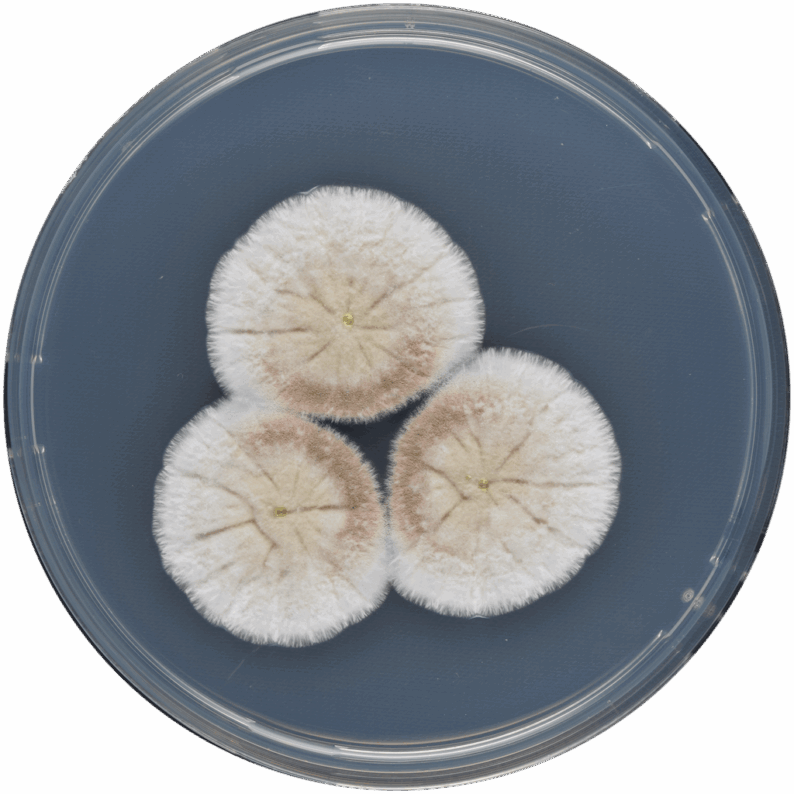

A Deeper Look into Fungal Species Reveals Biomanufacturing Potential
JBEI researchers investigate the connections between Aspergillus species, demonstrating their usefulness for producing biofuels and bioproducts.
September 29, 2025

Brett Helms Honored by American Chemical Society
Helms, Scientific Lead of New Pathway Development, received the 2025 Henry H. Storch Award in Energy Chemistry.
September 10, 2025

Jay Keasling Named 2025 DOE/NAI Innovator of the Year
Keasling, one of the foremost authorities on synthetic biology, was recognized for being a prolific inventor and entrepreneur.
June 25, 2025

Shih Honored by American Society of Plant Biologists
Shih was recognized for outstanding investigations in the field of plant biology.
May 20, 2025

Illuminating a Plant Engineering "Black Box" Yields Biomanufacturing Improvements
JBEI researchers make major advancements on a cornerstone plant engineering tool.
May 12, 2025

How Berkeley Lab is Leading the Biology-Based Industrial Revolution
Berkeley Lab scientists, including scientists at JBEI, are playing a key role in shaping the future of biomanufacturing.
May 01, 2025

Expert Interview: Blake Simmons
Blake Simmons describes how biomanufacturing supports the U.S. goal of increased domestic production in an audio interview.
May 01, 2025

Harnessing Artificial Intelligence for High-Impact Science
Berkeley Lab researchers, including JBEI's Héctor García Martín, are using the latest AI technologies to drive U.S. research.
April 30, 2025



